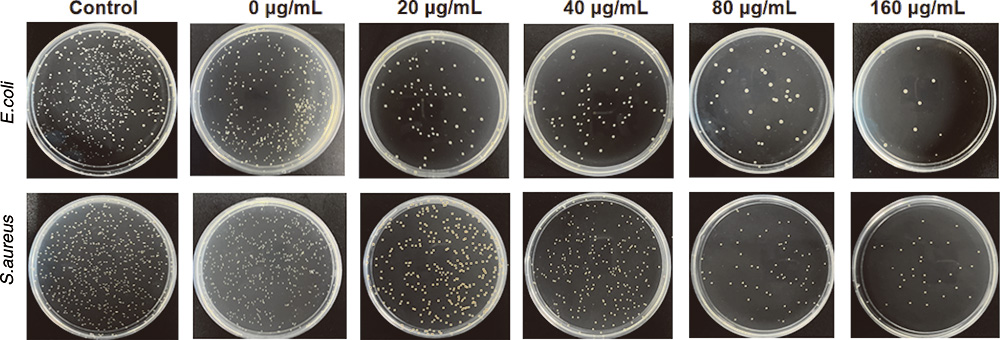
负载MXene纳米片的冻融水凝胶的制备及防治术后胰瘘的研究-水凝胶抗大肠杆菌、金黄色葡萄球菌效果图7 负载MXene纳米片的冻融水凝胶的制备及防治术后胰瘘的研究-水凝胶抗大肠杆菌、金黄色葡萄球菌效果图7

近年来,随着二维纳米材料MXene在生物医学领域的突破性进展,其与天然/合成高分子复合构建的功能性水凝胶正成为组织修复与抗感染治疗的新热点。近期一项研究通过LiF/HCl选择性刻蚀MAX相(如Ti₃AlC₂)中的Al层,成功制备出具有高比表面积和丰富表面官能团的Ti3C3Tₓ MXene纳米片,并将其负载于聚乙烯醇(PVA)与壳聚糖(CS)基质中,通过反复冻融法构建了PVA-CS-MXene复合水凝胶。该材料展现出优异的力学强度、可控溶胀行为、可降解性,同时具备显著的抗菌活性与生物相容性,在大鼠术后胰瘘模型中有效促进残余胰腺创面愈合,为临床防治这一高致死率并发症提供了全新思路。
作为国内领先的高端复杂制剂CDMO企业,中新康明已成功完成PVA-CS-MXene水凝胶的工艺开发与放大验证,并全面开放该平台的处方优化、GMP级制备、分析检测及注册申报支持服务,助力科研成果高效转化为临床可用产品。

一、成熟工艺平台:实现PVA-CS-MXene水凝胶的稳定可控制备
中新康明基于对高分子物理交联机制的深入理解,建立了标准化的反复冻融法制备流程。我们精准控制冷冻温度(-20℃至-80℃梯度)、解冻速率、循环次数(3–5次)及MXene分散均匀性,确保水凝胶网络结构致密且MXene纳米片均匀分布,避免团聚导致的性能下降。针对MXene易氧化的特性,我们在惰性气氛(N₂/Ar)下完成关键混合与成型步骤,并优化储存条件,显著提升产品稳定性。
更重要的是,我们已实现从实验室克级到公斤级的大包装生产能力。无论是用于动物实验的预灌装小规格样品,还是面向临床试验的批量供应(如50g/100g/500g无菌独立包装),中新康明均可按需定制,满足不同研发阶段的需求。
二、全方位检测与验证服务:数据驱动质量与功效确认
为全面评估PVA-CS-MXene水凝胶的安全性与有效性,中新康明提供覆盖理化、生物学、药效学三大维度的检测服务:
理化性能表征:
力学强度(压缩模量、拉伸强度)、溶胀率(PBS/pH 7.4, 37℃)、体外降解动力学(质量损失率、形貌变化)、MXene载量(ICP-MS/TGA)、微观结构(SEM/TEM观察网络与纳米片分布)。
生物安全性评价:
按照ISO 10993标准,开展L929细胞毒性测试(MTT/CCK-8法)、溶血性、皮肤致敏性及全身毒性评估,确保材料符合医疗器械/局部给药产品的安全门槛。
抗菌与抗炎功效验证:
对大肠杆菌(E. coli)和金黄色葡萄球菌(S. aureus)进行抑菌圈、MIC/MBC测定;建立LPS诱导的RAW264.7巨噬细胞炎症模型,检测TNF-α、IL-6等炎症因子水平,验证其抑制炎症反应的能力。
体内药效学支持:
合作CRO机构开展大鼠术后胰瘘模型研究,评估水凝胶对残余胰腺创面愈合速度、纤维化程度、感染控制及生存率的影响,提供IND申报所需的非临床有效性数据。

三、CDMO全链条服务:从处方优化到商业化落地
中新康明不仅提供“来料加工”,更致力于成为客户在高端水凝胶制剂开发中的战略合作伙伴:
处方工艺优化:
针对不同适应症(如胰瘘、慢性伤口、术后防粘连),调整PVA/CS比例、MXene浓度、交联密度,平衡力学性能、降解速率与药物释放行为。
GMP合规生产:
在B+A级洁净环境下完成无菌配制、灌装与密封,配备在线环境监测系统,确保产品无菌保障水平(SAL ≤10⁻⁶)。
CMC与注册支持:
编写完整的CTD格式CMC模块,包括处方工艺描述、关键质量属性(CQAs)、稳定性研究方案(加速/长期)、分析方法验证报告等,支持NMPA/FDA/EMA申报。
技术转移与放大:
提供从小试到中试再到商业化生产的无缝技术转移服务,确保工艺稳健性和批间一致性。

四、差异化优势:聚焦前沿递送系统,打造水凝胶CDMO标杆
中新康明深耕脂质体、LNP、微球、水凝胶等先进递送平台多年,在PVA-CS-MXene这类“纳米复合水凝胶”领域具备独特优势:
拥有MXene分散与稳定化专有技术;
熟悉天然高分子(壳聚糖、透明质酸)与合成高分子(PVA、PLGA)的复合工艺;
具备医疗器械与药品双轨注册经验;
可联动公司内部LNP/mRNA平台,拓展多功能复合水凝胶(如载siRNA+MXene协同抗炎)。
结语
PVA-CS-MXene水凝胶代表了“纳米材料+智能高分子”在术后创面管理中的创新融合。中新康明以扎实的制剂开发能力、完善的GMP体系与全链条CDMO服务,全力推动此类前沿成果从论文走向病床。我们诚邀高校、医院、Biotech企业合作,共同加速这一极具潜力的术后胰瘘防治策略的临床转化。
返回